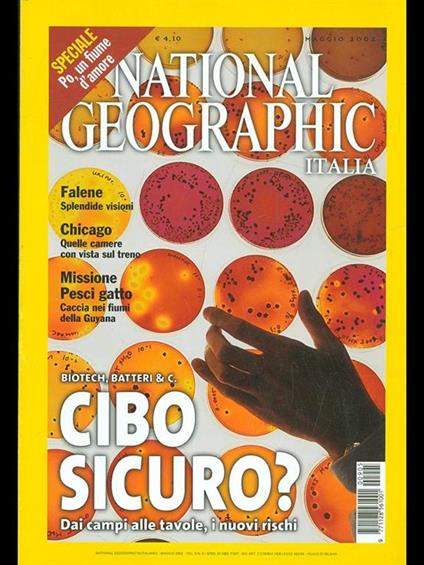
National Geographic Italia. Maggio 2002Vol. 9 N. 5 - copertina

National Geographic Italia. Maggio 2002Vol. 9 N. 5
Prezzo minimo ultimi 30 giorni: 4,48 €
Condizioni copertina: Buone
Condizioni pagine: Buone
Venditore:

Immagini:



-
Editore:
-
Tipologia:
-
Anno edizione:2002
- Prodotto usato
- Condizioni: Usato - In buone condizioni
Le schede prodotto sono aggiornate in conformità al Regolamento UE 988/2023. Laddove ci fossero taluni dati non disponibili per ragioni indipendenti da Feltrinelli, vi informiamo che stiamo compiendo ogni ragionevole sforzo per inserirli. Vi invitiamo a controllare periodicamente il sito www.lafeltrinelli.it per eventuali novità e aggiornamenti.
Per le vendite di prodotti da terze parti, ciascun venditore si assume la piena e diretta responsabilità per la commercializzazione del prodotto e per la sua conformità al Regolamento UE 988/2023, nonché alle normative nazionali ed europee vigenti.
Per informazioni sulla sicurezza dei prodotti, contattare productsafety@feltrinelli.it